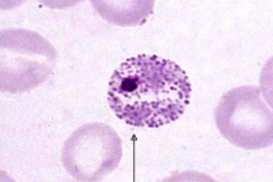
term image

parasite identification
1/79
There's no tags or description
Looks like no tags are added yet.
Name | Mastery | Learn | Test | Matching | Spaced | Call with Kai |
|---|
No analytics yet
Send a link to your students to track their progress
80 Terms

entamoeba histolytica
cystic stage
amoebiasis

entamoeba histolytica
trophozoite forma magna
amoebiasis

trypanosoma gambiense
african sleeping sickness/trypanosomiasis

trypanosoma gamiense
trypanosomiasis

trypanosoma gambiense
trypanosomiasis

trypanosoma cruzi
Chagas disease

trypanosoma cruzi
Chagas disease

Leishmania donovani (promastigote form)
visceral leishmaniasis, kaza-azar

Leishmania donovani (promastigote form)
visceral leishmaniasis, kaza-azar

Leishmania donovani (promastigote form)
visceral leishmaniasis, kaza-azar

Trichomonas vaginalis
trichomoniasis

Trichomonas vaginalis
trichomoniasis

Trichomonas vaginalis
trichomoniasis

Trichomonas vaginalis
trichomoniasis

Giardia lamblia
giardiasis

Giardia lamblia
giardiasis

Giardia lamblia
giardiasis

Giardia lamblia
giardiasis

Balantidum coli
balantidiasis

Balantidum coli
balantidiasis

Balantidum coli
balantidiasis

Toxoplasma gondii
toxoplasmosis

Toxoplasma gondii
toxoplasmosis

Toxoplasma gondii
toxoplasmosis
Plasmodium
malaria

Plasmodium
malaria

Plasmodium
malaria

Fasciola hepatica
fascioliasis

Fasciola hepatica
fascioliasis

Dicrocoelium lanceatum/dendriticum/
Opisthorchis felineus
dicoceliasis, opisthorhiasis

Dicrocoelium lanceatum/dendriticum (lancet fluke) Opisthorchis felineus
dicoceliasis, opisthorhiasis

Schistosoma
schistosomiasis

Schistosoma
schistosomiasis

Taenia solium
taeniasis, cysticercosis

Taenia solium
taeniasis, cysticercosis

Taenia solium
taeniasis, cysticercosis

Taeniarhynchus saginatus (beef tapeworm)
taeniarhynchosis

Taeniarhynchus saginatus (beef tapeworm)
taeniarhynchosis

Diphyllobothrium latum (fish tapeworm)
diphyllobothriasis

Diphyllobothrium latum (fish tapeworm)
diphyllobothriasis

Diphyllobothrium latum (fish tapeworm)
diphyllobothriasis

Echinococcus granulosus (dog tapeworm)
echinococcosis (hydatid disease)

Echinococcus granulosus (dog tapeworm)
echinococcosis (hydatid disease)

Echinococcus granulosus (dog tapeworm)
echinococcosis (hydatid disease)

Hymenolepis nana (dwarf tapeworm)
hymenolepidiasis

Hymenolepis nana (dwarf tapeworm)
hymenolepidiasis

Hymenolepis nana (dwarf tapeworm)
hymenolepidiasis

Ascaris lumbricoides (round worm)
ascariasis

Ascaris lumbricoides (round worm)
ascariasis

Ascaris lumbricoides (round worm)
ascariasis

Enterobius (Oxyuris) vermicularis (pinworm)
enterobiasis

Enterobius (Oxyuris) vermicularis (pinworm)
enterobiasis

Enterobius (Oxyuris) vermicularis (pinworm)
enterobiasis

Trichuris trichura (whipworm)
trichuriasis, whipworm infection

Trichuris trichura (whipworm)
trichuriasis, whipworm infection

Trichuris trichura (whipworm)
trichuriasis, whipworm infection

Trichinella spiralis (trichuna worm)
trichinosis, trichiniasis

Trichinella spiralis (trichuna worm)
trichinosis, trichiniasis

Trichinella spiralis (trichuna worm)
trichinosis, trichiniasis

Ancylostoma duodenale (hookworm)
ancylostomiasis

Ancylostoma duodenale (hookworm)
ancylostomiasis

Ancylostoma duodenale (hookworm)
ancylostomiasis

Strongyloides stercoralis
strongyloidosis

Dracunculus medinensis (guinea worm)
dracunculiasis, dracontiasis

Dracunculus medinensis (guinea worm)
dracunculiasis, dracontiasis

Wuchereria (Filaria) bancrofti
filariasis

Wuchereria (Filaria) bancrofti
filariasis

Acarina (ticks)
acaridosis

Sarcoptes scabiei
scabies rash

Pediculus capitis (hair louse)
pediculosis

Pediculus capitis (hair louse)
pediculosis

Phthirius pubis (crab louse)
phthiriasis

Pulex irritans (human flea)
– transmissive infections

Cimex lectularius (reduviid bugs)
– transmissive infections

Blatta orientalis (black-beetle)
– transmissive infections

anopheles
transmissive infections

anopheles
transmissive infections

Phlebotomus papatasii vector and intermediate host of protozoans causing leshmaniasis; vector of the virus responsible for sandfly fever

Musca domestica (housefly) disease – transmissive diseases

Glossina palpalis (Tsetse fly)
transmissive infections vector and intermediate host of T. gambiense